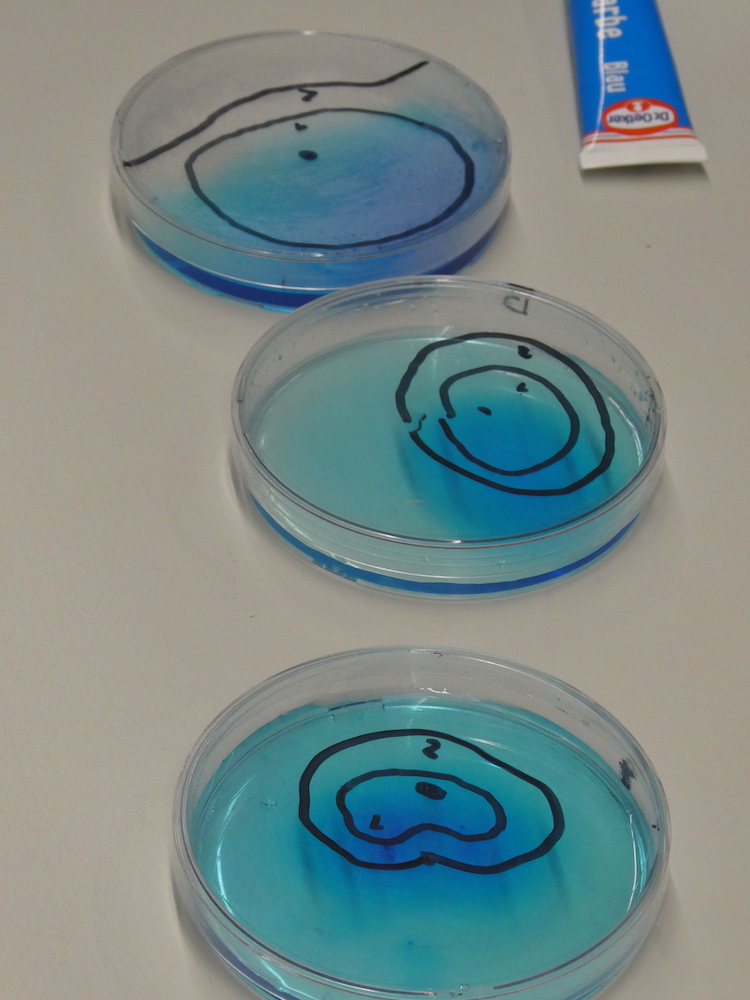

Besuch im Biologieinstitut
der E02 (Tutorium Borsch)
Das E02- Tutorium von Frau Borsch hatte am Donnerstag, 29. Februar die Gelegenheit, im Rahmen eines Schülerlabortags im Biologieinstitut der Goethe Universität grundlegende Versuche zur Diffusion und Osmose durchzuführen (erfolgreich!!) und dadurch ihre theoretisch erworbenen Kenntnisse in die Praxis umzusetzen.